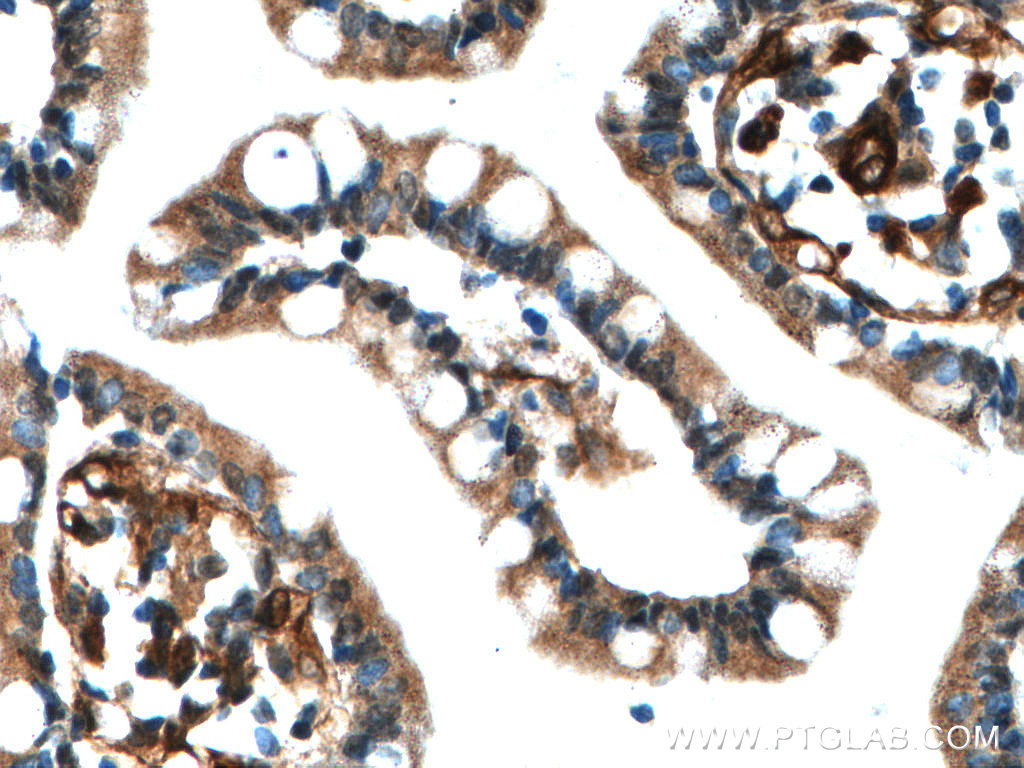

验证数据展示
经过测试的应用
| Positive WB detected in | HEK-293T cells, human brain tissue, mouse colon tissue, SH-SY5Y cells, rat brain tissue, PC-12 cells, HeLa cells, MCF-7 cells, mouse lung tissue |
| Positive IP detected in | SH-SY5Y cells |
| Positive IHC detected in | human small intestine tissue, mouse brain tissue Note: suggested antigen retrieval with TE buffer pH 9.0; (*) Alternatively, antigen retrieval may be performed with citrate buffer pH 6.0 |
| Positive IF/ICC detected in | HEK-293 cells |
推荐稀释比
| 应用 | 推荐稀释比 |
|---|---|
| Western Blot (WB) | WB : 1:500-1:1000 |
| Immunoprecipitation (IP) | IP : 0.5-4.0 ug for 1.0-3.0 mg of total protein lysate |
| Immunohistochemistry (IHC) | IHC : 1:50-1:500 |
| Immunofluorescence (IF)/ICC | IF/ICC : 1:200-1:800 |
| It is recommended that this reagent should be titrated in each testing system to obtain optimal results. | |
| Sample-dependent, Check data in validation data gallery. | |
产品信息
20229-1-AP targets RAB11A in WB, IHC, IF/ICC, IP, ELISA applications and shows reactivity with human, mouse, rat samples.
| 经测试应用 | WB, IHC, IF/ICC, IP, ELISA Application Description |
| 文献引用应用 | WB, IHC, IF |
| 经测试反应性 | human, mouse, rat |
| 文献引用反应性 | human, mouse, rat, canine |
| 免疫原 |
Peptide 种属同源性预测 |
| 宿主/亚型 | Rabbit / IgG |
| 抗体类别 | Polyclonal |
| 产品类型 | Antibody |
| 全称 | RAB11A, member RAS oncogene family |
| 别名 | RAB11A-Specific, Rab 11, RAB11, RAB11A/B, EC:3.6.5.2 |
| 计算分子量 | 24 kDa |
| 观测分子量 | 24 kDa |
| GenBank蛋白编号 | NM_004663 |
| 基因名称 | RAB11A |
| Gene ID (NCBI) | 8766 |
| RRID | AB_10666202 |
| 偶联类型 | Unconjugated |
| 形式 | Liquid |
| 纯化方式 | Antigen affinity purification |
| UNIPROT ID | P62491 |
| 储存缓冲液 | PBS with 0.02% sodium azide and 50% glycerol, pH 7.3. |
| 储存条件 | Store at -20°C. Stable for one year after shipment. Aliquoting is unnecessary for -20oC storage. |
背景介绍
Rab11a, Rab11b and Rab25 comprise a subfamily of Rab proteins that belong to the Ras-related small GTPase protein superfamily (PMID: 8074219, PMID: 10708602). Rab11 proteins are involved in endocytosis and plasma membrane recycling in non-polarized and polarized cells ( PMID: 8638719, PMID: 8922376). Rab11a and Rab11b are ubiquitously expressed in most tissues, while Rab25 is only expressed in epithelial cells. Rab11a is known to regulate the recycling of internalized cell surface proteins and receptors from the early endosome through the trans-Golgi network (PMID: 11121436, PMID: 9600939). The antibody is specific to RAB11A, and has no cross reaction to RAB11B.
实验方案
| Product Specific Protocols | |
|---|---|
| IF protocol for RAB11A antibody 20229-1-AP | Download protocol |
| IHC protocol for RAB11A antibody 20229-1-AP | Download protocol |
| IP protocol for RAB11A antibody 20229-1-AP | Download protocol |
| WB protocol for RAB11A antibody 20229-1-AP | Download protocol |
| Standard Protocols | |
|---|---|
| Click here to view our Standard Protocols |
发表文章
| Species | Application | Title |
|---|---|---|
J Thromb Haemost Increased potency of recombinant VWF D'D3 albumin fusion proteins engineered for enhanced affinity for coagulation factor VIII. | ||
Proc Natl Acad Sci U S A ARL13B, PDE6D, and CEP164 form a functional network for INPP5E ciliary targeting.
| ||
J Cell Biol BLOC-1 is required for selective membrane protein trafficking from endosomes to primary cilia. | ||
EMBO Rep Amino acid starvation-induced LDLR trafficking accelerates lipoprotein endocytosis and LDL clearance. | ||
Cell Mol Gastroenterol Hepatol Rab9 Mediates Pancreatic Autophagy Switch From Canonical to Noncanonical, Aggravating Experimental Pancreatitis. | ||
Br J Pharmacol An orally available hypoglycaemic peptide taken up by caveolae transcytosis displays improved hypoglycaemic effects and body weight control in db/db mice. |